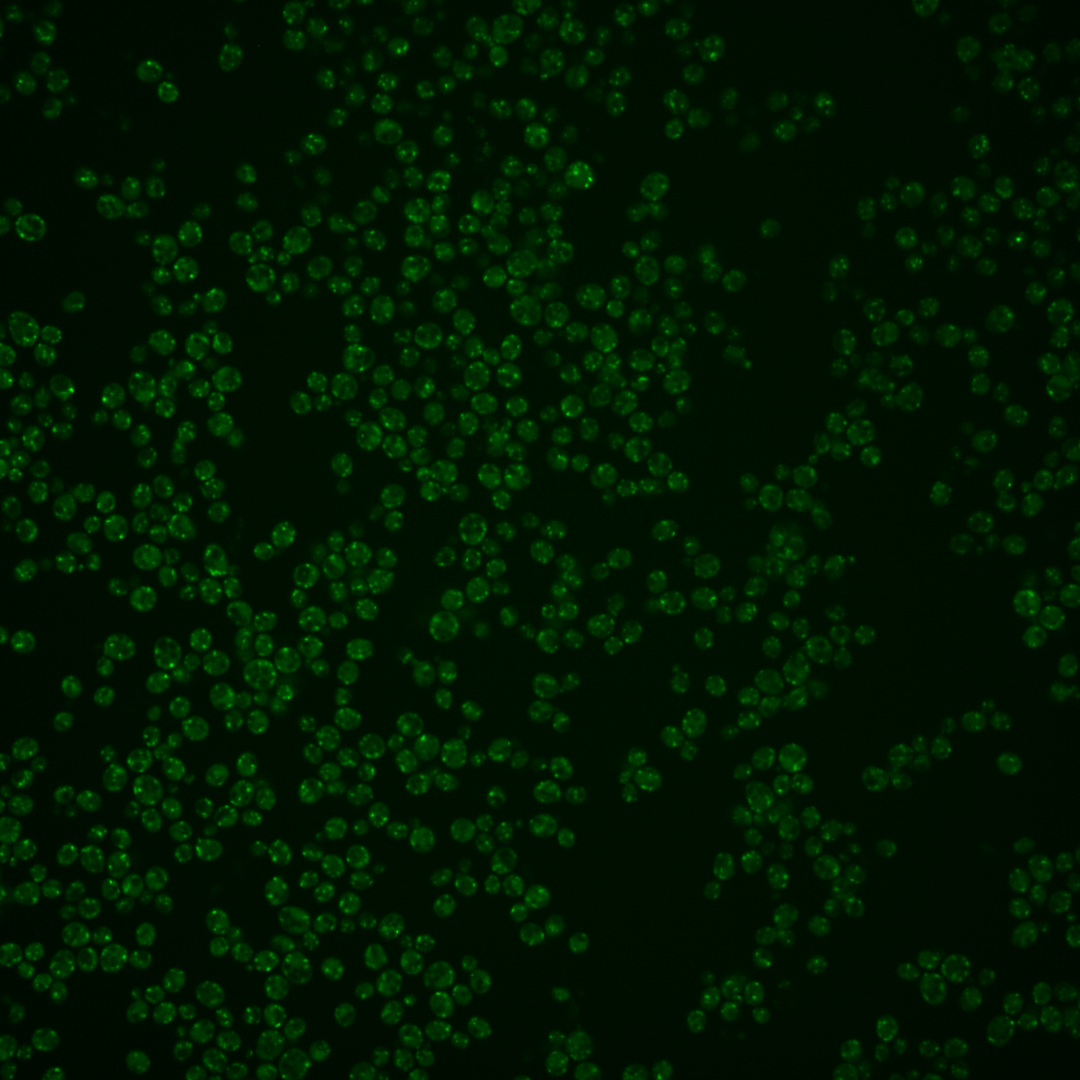
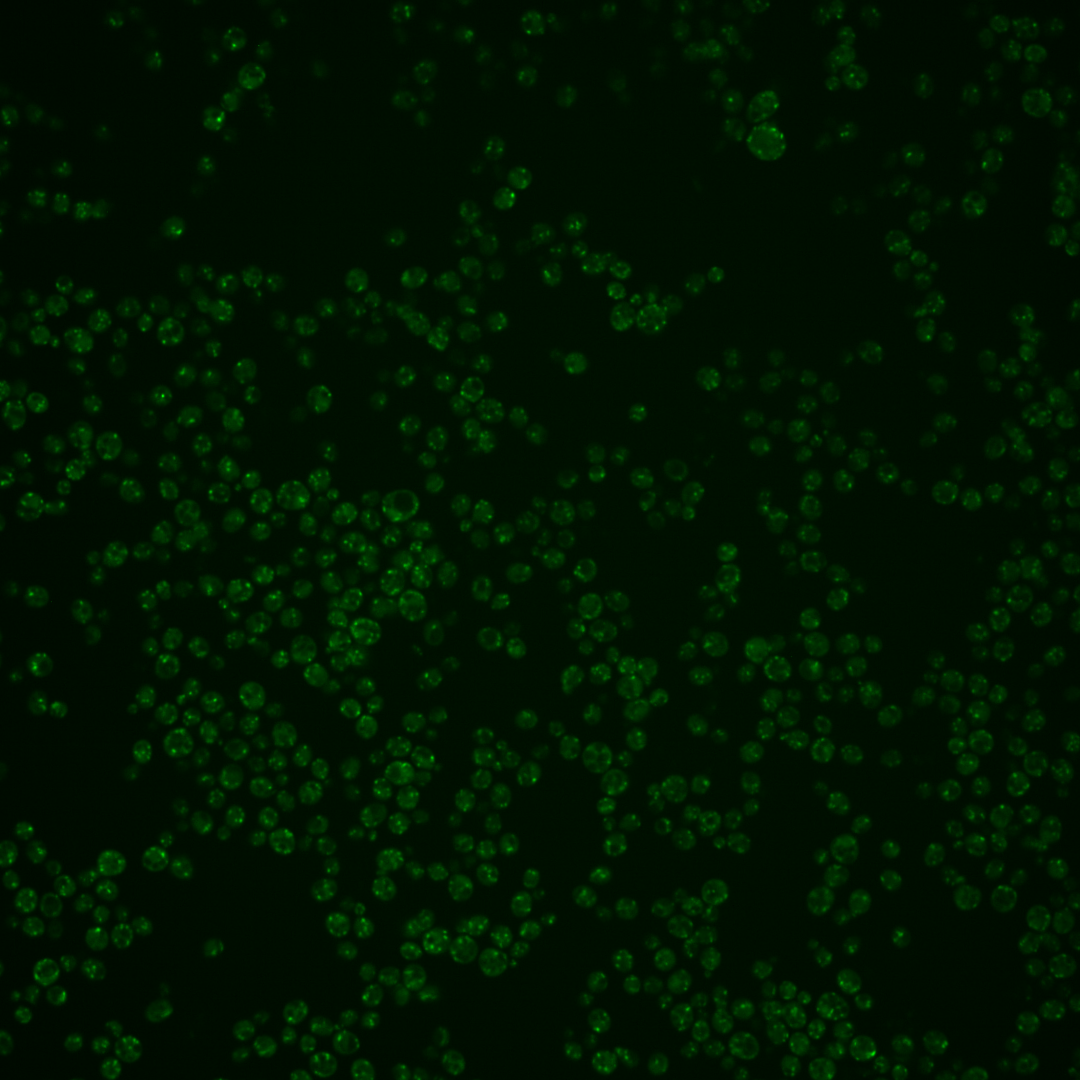

| Standard name | |
|---|---|
| Human Ortholog | |
| Description | Golgi-localized, leucine-zipper domain containing protein; involved in endosome to Golgi transport, organization of the ER, establishing cell polarity, and morphogenesis; detected in highly purified mitochondria in high-throughput studies |
Micrographs




















































































Sub-cellular Localization
Yeast GFP Assignment
Protein Abundance
Localization Change
External localization resources
| ensLOC | DeepLoc | |||||||||||||||||||||||
|---|---|---|---|---|---|---|---|---|---|---|---|---|---|---|---|---|---|---|---|---|---|---|---|---|
| Localization | WT1 | WT2 | WT3 | RAP60 | RAP140 | RAP220 | RAP300 | RAP380 | RAP460 | RAP540 | RAP620 | RAP700 | HU80 | HU120 | HU160 | rpd3Δ_1 | rpd3Δ_2 | rpd3Δ_3 | WT1 | WT2 | WT3 | AF100 | AF140 | AF180 |
| Cortical Patches | 14 | 3 | 3 | 1 | 2 | 2 | 1 | 1 | 1 | 3 | 0 | 1 | 7 | 2 | 7 | – | – | – | 6 | 1 | 5 | 13 | 29 | 31 |
| Bud | 2 | 2 | 4 | 4 | 7 | 21 | 18 | 26 | 10 | 15 | 7 | 7 | 7 | 7 | 8 | – | – | – | 0 | 0 | 0 | 0 | 0 | 1 |
| Bud Neck | 0 | 0 | 0 | 0 | 0 | 0 | 0 | 0 | 0 | 0 | 0 | 0 | 0 | 0 | 0 | – | – | – | 0 | 0 | 0 | 0 | 0 | 0 |
| Bud Site | 0 | 0 | 0 | 0 | 0 | 0 | 0 | 6 | 3 | 2 | 4 | 3 | 0 | 0 | 0 | – | – | – | – | – | – | – | – | – |
| Cell Periphery | 0 | 0 | 0 | 0 | 1 | 0 | 0 | 2 | 1 | 2 | 0 | 0 | 2 | 0 | 0 | – | – | – | 0 | 0 | 0 | 0 | 0 | 0 |
| Cytoplasm | 11 | 1 | 4 | 11 | 14 | 13 | 12 | 20 | 5 | 8 | 3 | 10 | 7 | 12 | 11 | – | – | – | 2 | 0 | 0 | 2 | 2 | 0 |
| Endoplasmic Reticulum | 3 | 4 | 6 | 4 | 4 | 5 | 4 | 0 | 2 | 3 | 0 | 1 | 4 | 2 | 4 | – | – | – | 1 | 0 | 0 | 1 | 1 | 2 |
| Endosome | 35 | 1 | 1 | 1 | 25 | 4 | 10 | 6 | 1 | 0 | 1 | 4 | 43 | 65 | 42 | – | – | – | 37 | 13 | 15 | 28 | 51 | 23 |
| Golgi | 143 | 23 | 6 | 2 | 9 | 4 | 4 | 0 | 0 | 0 | 0 | 2 | 103 | 166 | 89 | – | – | – | 210 | 60 | 59 | 143 | 299 | 297 |
| Mitochondria | 78 | 54 | 100 | 101 | 167 | 188 | 229 | 214 | 162 | 154 | 59 | 140 | 167 | 217 | 296 | – | – | – | 8 | 2 | 9 | 10 | 7 | 5 |
| Nucleus | 2 | 0 | 0 | 2 | 1 | 2 | 2 | 3 | 0 | 3 | 1 | 1 | 0 | 0 | 1 | – | – | – | 0 | 0 | 0 | 0 | 0 | 0 |
| Nuclear Periphery | 1 | 5 | 2 | 0 | 1 | 1 | 5 | 2 | 4 | 4 | 0 | 2 | 0 | 2 | 4 | – | – | – | 1 | 0 | 0 | 0 | 0 | 0 |
| Nucleolus | 2 | 0 | 3 | 0 | 4 | 5 | 11 | 7 | 2 | 6 | 1 | 5 | 4 | 15 | 10 | – | – | – | 0 | 0 | 0 | 0 | 0 | 0 |
| Peroxisomes | 3 | 0 | 1 | 2 | 18 | 6 | 5 | 13 | 6 | 10 | 5 | 2 | 13 | 9 | 7 | – | – | – | 9 | 2 | 16 | 7 | 13 | 23 |
| SpindlePole | 12 | 0 | 1 | 0 | 9 | 3 | 3 | 13 | 1 | 7 | 0 | 4 | 4 | 3 | 3 | – | – | – | 1 | 0 | 0 | 0 | 0 | 0 |
| Vac/Vac Membrane | 33 | 5 | 7 | 2 | 5 | 5 | 8 | 9 | 2 | 1 | 3 | 4 | 16 | 15 | 24 | – | – | – | 2 | 1 | 2 | 2 | 2 | 0 |
| Unique Cell Count | 240 | 66 | 107 | 113 | 208 | 217 | 257 | 256 | 168 | 170 | 69 | 154 | 267 | 351 | 376 | 289 | 86 | 112 | 211 | 414 | 390 | |||
| Labelled Cell Count | 339 | 98 | 138 | 130 | 267 | 259 | 312 | 322 | 200 | 218 | 84 | 186 | 377 | 515 | 506 | 289 | 86 | 112 | 211 | 414 | 390 | |||
Yeast GFP Assignment
Protein Abundance
| Screen | WT1 | WT2 | WT3 | RAP60 | RAP140 | RAP220 | RAP300 | RAP380 | RAP460 | RAP540 | RAP620 | RAP700 | HU80 | HU120 | HU160 | rpd3Δ_1 | rpd3Δ_2 | rpd3Δ_3 | AF100 | AF140 | AF180 |
|---|---|---|---|---|---|---|---|---|---|---|---|---|---|---|---|---|---|---|---|---|---|
| Mean Cell GFP Intensity (1e-4) | 11.4 | 8.5 | 5.8 | 5.7 | 6.2 | 6.0 | 5.6 | 5.6 | 5.2 | 5.1 | 4.7 | 4.9 | 9.8 | 9.6 | 8.4 | – | – | – | 10.0 | 10.1 | 10.9 |
| Std Deviation (1e-4) | 1.6 | 1.9 | 1.0 | 0.9 | 1.2 | 1.4 | 1.2 | 1.3 | 1.4 | 1.1 | 0.8 | 1.0 | 1.4 | 1.4 | 1.4 | – | – | – | 1.2 | 1.6 | 1.6 |
| Intensity Change (Log2) | – | – | – | -0.03 | 0.08 | 0.04 | -0.05 | -0.07 | -0.18 | -0.21 | -0.31 | -0.27 | 0.74 | 0.71 | 0.52 | – | – | – | 0.78 | 0.78 | 0.9 |
Localization Change
| Localization | RAP60 | RAP140 | RAP220 | RAP300 | RAP380 | RAP460 | RAP540 | RAP620 | RAP700 | HU80 | HU120 | HU160 | rpd3Δ_1 | rpd3Δ_2 | rpd3Δ_3 |
|---|---|---|---|---|---|---|---|---|---|---|---|---|---|---|---|
| Actin | – | – | – | – | – | – | – | – | – | – | – | – | – | – | – |
| Bud | 0 | 0 | 1.9 | 1.2 | 2.0 | 0.8 | 1.6 | – | 0 | 0 | 0 | 0 | – | – | – |
| Bud Neck | 0 | 0 | 0 | 0 | 0 | 0 | 0 | – | 0 | 0 | 0 | 0 | – | – | – |
| Bud Site | 0 | 0 | 0 | 0 | 0 | 0 | 0 | – | 0 | 0 | 0 | 0 | – | – | – |
| Cell Periphery | 0 | 0 | 0 | 0 | 0 | 0 | 0 | – | 0 | 0 | 0 | 0 | – | – | – |
| Cyto | – | – | – | – | – | – | – | – | – | – | – | – | – | – | – |
| Endoplasmic Reticulum | 0 | 0 | 0 | 0 | 0 | 0 | 0 | – | 0 | 0 | 0 | 0 | – | – | – |
| Endosome | 0 | 3.4 | 0 | 0 | 0 | 0 | 0 | – | 0 | 4.1 | 4.5 | 3.3 | – | – | – |
| Golgi | 0 | -0.5 | 0 | 0 | 0 | 0 | 0 | – | 0 | 6.3 | 7.8 | 4.1 | – | – | – |
| Mitochondria | -1.1 | -3.1 | -1.8 | -1.3 | -2.5 | 1.1 | -0.8 | – | 0 | -6.0 | -6.2 | -3.5 | – | – | – |
| Nuclear Periphery | 0 | 0 | 0 | 0 | 0 | 0 | 0 | – | 0 | 0 | 0 | 0 | – | – | – |
| Nuc | – | – | – | – | – | – | – | – | – | – | – | – | – | – | – |
| Nucleolus | 0 | 0 | 0 | 0 | 0 | 0 | 0 | – | 0 | 0 | 0 | 0 | – | – | – |
| Peroxisomes | 0 | 2.7 | 0 | 0 | 0 | 0 | 0 | – | 0 | 0 | 0 | 0 | – | – | – |
| SpindlePole | 0 | 0 | 0 | 0 | 0 | 0 | 0 | – | 0 | 0 | 0 | 0 | – | – | – |
| Vac | – | – | – | – | – | – | – | – | – | – | – | – | – | – | – |
| Cortical Patches | 0 | 0 | 0 | 0 | 0 | 0 | 0 | – | 0 | 0 | 0 | 0 | – | – | – |
| Cytoplasm | 1.8 | 1.1 | 0.9 | 0 | 1.4 | 0 | 0 | – | 1.0 | 0 | 0 | 0 | – | – | – |
| Nucleus | 0 | 0 | 0 | 0 | 0 | 0 | 0 | – | 0 | 0 | 0 | 0 | – | – | – |
| Vacuole | 0 | 0 | 0 | 0 | 0 | 0 | 0 | – | 0 | -0.2 | -1.0 | -0.1 | – | – | – |
External localization resources
Images
Protein Concentration and Protein Localization Data
| R1 | R2 | R3 | ||||||||||||||||
|---|---|---|---|---|---|---|---|---|---|---|---|---|---|---|---|---|---|---|
| G1 Pre-START | G1 Post-START | S/G2 | Metaphase | Anaphase | Telophase | G1 Pre-START | G1 Post-START | S/G2 | Metaphase | Anaphase | Telophase | G1 Pre-START | G1 Post-START | S/G2 | Metaphase | Anaphase | Telophase | |
| Concentration | – | – | – | – | – | – | – | – | – | – | – | – | – | – | – | – | – | – |
| Actin | – | – | – | – | – | – | – | – | – | – | – | – | – | – | – | – | – | – |
| Bud | – | – | – | – | – | – | – | – | – | – | – | – | – | – | – | – | – | – |
| Bud Neck | – | – | – | – | – | – | – | – | – | – | – | – | – | – | – | – | – | – |
| Bud Periphery | – | – | – | – | – | – | – | – | – | – | – | – | – | – | – | – | – | – |
| Bud Site | – | – | – | – | – | – | – | – | – | – | – | – | – | – | – | – | – | – |
| Cell Periphery | – | – | – | – | – | – | – | – | – | – | – | – | – | – | – | – | – | – |
| Cytoplasm | – | – | – | – | – | – | – | – | – | – | – | – | – | – | – | – | – | – |
| Cytoplasmic Foci | – | – | – | – | – | – | – | – | – | – | – | – | – | – | – | – | – | – |
| Eisosomes | – | – | – | – | – | – | – | – | – | – | – | – | – | – | – | – | – | – |
| Endoplasmic Reticulum | – | – | – | – | – | – | – | – | – | – | – | – | – | – | – | – | – | – |
| Endosome | – | – | – | – | – | – | – | – | – | – | – | – | – | – | – | – | – | – |
| Golgi | – | – | – | – | – | – | – | – | – | – | – | – | – | – | – | – | – | – |
| Lipid Particles | – | – | – | – | – | – | – | – | – | – | – | – | – | – | – | – | – | – |
| Mitochondria | – | – | – | – | – | – | – | – | – | – | – | – | – | – | – | – | – | – |
| None | – | – | – | – | – | – | – | – | – | – | – | – | – | – | – | – | – | – |
| Nuclear Periphery | – | – | – | – | – | – | – | – | – | – | – | – | – | – | – | – | – | – |
| Nucleolus | – | – | – | – | – | – | – | – | – | – | – | – | – | – | – | – | – | – |
| Nucleus | – | – | – | – | – | – | – | – | – | – | – | – | – | – | – | – | – | – |
| Peroxisomes | – | – | – | – | – | – | – | – | – | – | – | – | – | – | – | – | – | – |
| Punctate Nuclear | – | – | – | – | – | – | – | – | – | – | – | – | – | – | – | – | – | – |
| Vacuole | – | – | – | – | – | – | – | – | – | – | – | – | – | – | – | – | – | – |
| Vacuole Periphery | – | – | – | – | – | – | – | – | – | – | – | – | – | – | – | – | – | – |
Sequencing Data
| R1 | R2 | |||||||||
|---|---|---|---|---|---|---|---|---|---|---|
| G1 Post-START | S/G2 | Metaphase | Anaphase | Telophase | G1 Post-START | S/G2 | Metaphase | Anaphase | Telophase | |
| Gene Expression | 25.5448 | 20.9003 | 24.6994 | 34.658 | 24.1382 | 23.1507 | 28.372 | 31.1669 | 30.0905 | 37.0827 |
| Translational Efficiency | 0.6136 | 0.5718 | 0.5327 | 0.5004 | 0.5567 | 0.603 | 0.5446 | 0.388 | 0.4757 | 0.4372 |
Hit Data
| Dataset | Hit |
|---|---|
| Protein Concentration | – |
| Protein Localization | – |
| Gene Expression | ✘ |
| Translational Efficiency | ✘ |
Micrographs
































Cell Count
| R1 | R2 | R1 & R2 | |||||||||
|---|---|---|---|---|---|---|---|---|---|---|---|
| WT | UBP2 | UBP14 | UBP2UBP14 | WT | UBP2 | UBP14 | UBP2UBP14 | WT | UBP2 | UBP14 | UBP2UBP14 |
| 475 | 1537 | 1139 | 1497 | 1615 | 2047 | 1033 | 2152 | 2090 | 3584 | 2172 | 3649 |
Protein Abundance
| R1 | R2 | R1 & R2 | ||||||||||
|---|---|---|---|---|---|---|---|---|---|---|---|---|
| WT | UBP2 | UBP14 | UBP2UBP14 | WT | UBP2 | UBP14 | UBP2UBP14 | WT | UBP2 | UBP14 | UBP2UBP14 | |
| Mean | 950.59 | 1028.41 | 1370.51 | 1232.78 | 837.65 | 1020.32 | 1193.80 | 1300.14 | 863.32 | 1023.79 | 1286.47 | 1272.51 |
| Standard Deviation | 177.82 | 155.59 | 186.04 | 185.98 | 128.35 | 145.57 | 165.48 | 207.64 | 148.85 | 150.00 | 197.39 | 201.78 |
| Intensity Change Log 2 | — | 0.113520 | 0.527818 | 0.375020 | — | 0.284602 | 0.511142 | 0.634248 | — | 0.196189 | 0.520030 | 0.502261 |
Localization Score (DeepLoc)
| R1 | R2 | R1 & R2 | ||||||||||
|---|---|---|---|---|---|---|---|---|---|---|---|---|
| WT | UBP2 | UBP14 | UBP2UBP14 | WT | UBP2 | UBP14 | UBP2UBP14 | WT | UBP2 | UBP14 | UBP2UBP14 | |
| Actin | 0.022020 | 0.003813 | 0.006020 | 0.001205 | 0.004279 | 0.003091 | 0.002516 | 0.009068 | 0.008311 | 0.003401 | 0.004354 | 0.005842 |
| Bud Neck | 0.000339 | 0.000131 | 0.001090 | 0.000693 | 0.000204 | 0.000063 | 0.000652 | 0.000210 | 0.000235 | 0.000092 | 0.000882 | 0.000408 |
| Bud Site | 0.001574 | 0.000641 | 0.002460 | 0.002335 | 0.000500 | 0.000410 | 0.001427 | 0.002454 | 0.000744 | 0.000509 | 0.001969 | 0.002405 |
| Cell Periphery | 0.000224 | 0.000037 | 0.000071 | 0.000043 | 0.000067 | 0.000045 | 0.000054 | 0.000080 | 0.000103 | 0.000041 | 0.000063 | 0.000065 |
| Cytoplasm | 0.001035 | 0.000392 | 0.000548 | 0.000981 | 0.000350 | 0.000269 | 0.000483 | 0.001436 | 0.000506 | 0.000322 | 0.000517 | 0.001249 |
| Cytoplasmic Foci | 0.129114 | 0.273723* | 0.169549 | 0.217737* | 0.209237* | 0.266643* | 0.324518* | 0.136665 | 0.191027* | 0.269680* | 0.243252* | 0.169925 |
| Eisosomes | 0.000214 | 0.000044 | 0.000036 | 0.000017 | 0.000068 | 0.000039 | 0.000029 | 0.000045 | 0.000101 | 0.000041 | 0.000032 | 0.000033 |
| Endoplasmic Reticulum | 0.002500 | 0.000228 | 0.001188 | 0.000392 | 0.000431 | 0.000170 | 0.000509 | 0.000284 | 0.000901 | 0.000195 | 0.000865 | 0.000328 |
| Endosome | 0.175753 | 0.171992 | 0.095173 | 0.318668* | 0.229677* | 0.204707* | 0.228517* | 0.170957 | 0.217422* | 0.190677 | 0.158591 | 0.231556* |
| Golgi | 0.578953* | 0.513775* | 0.651155* | 0.355640* | 0.492382* | 0.488035* | 0.337395* | 0.633458* | 0.512057* | 0.499074* | 0.501931* | 0.519483* |
| Lipid Particles | 0.018787 | 0.015683 | 0.020963 | 0.015636 | 0.026673 | 0.011429 | 0.047201 | 0.005411 | 0.024880 | 0.013254 | 0.033442 | 0.009606 |
| Mitochondria | 0.045443 | 0.008633 | 0.000807 | 0.003564 | 0.022698 | 0.013217 | 0.006008 | 0.004522 | 0.027868 | 0.011251 | 0.003281 | 0.004129 |
| Mitotic Spindle | 0.000884 | 0.001435 | 0.009051 | 0.019483 | 0.000723 | 0.001469 | 0.013508 | 0.003122 | 0.000760 | 0.001454 | 0.011171 | 0.009834 |
| None | 0.000065 | 0.000012 | 0.000021 | 0.000015 | 0.000047 | 0.000023 | 0.000017 | 0.000024 | 0.000051 | 0.000018 | 0.000019 | 0.000021 |
| Nuclear Periphery | 0.000502 | 0.000038 | 0.000937 | 0.000484 | 0.000039 | 0.000041 | 0.000535 | 0.000165 | 0.000144 | 0.000040 | 0.000746 | 0.000296 |
| Nuclear Periphery Foci | 0.001699 | 0.000156 | 0.004796 | 0.004608 | 0.000462 | 0.000204 | 0.003750 | 0.000690 | 0.000743 | 0.000183 | 0.004299 | 0.002297 |
| Nucleolus | 0.000017 | 0.000006 | 0.000013 | 0.000058 | 0.000155 | 0.000015 | 0.000044 | 0.000007 | 0.000124 | 0.000011 | 0.000028 | 0.000028 |
| Nucleus | 0.002221 | 0.000010 | 0.000023 | 0.000053 | 0.000154 | 0.000016 | 0.000057 | 0.000341 | 0.000624 | 0.000013 | 0.000039 | 0.000223 |
| Peroxisomes | 0.002344 | 0.003399 | 0.001590 | 0.003838 | 0.005639 | 0.004061 | 0.003759 | 0.002210 | 0.004890 | 0.003777 | 0.002622 | 0.002878 |
| Vacuole | 0.007455 | 0.002835 | 0.023686 | 0.040159 | 0.002550 | 0.002756 | 0.020764 | 0.018181 | 0.003665 | 0.002790 | 0.022296 | 0.027198 |
| Vacuole Periphery | 0.008859 | 0.003016 | 0.010824 | 0.014391 | 0.003662 | 0.003298 | 0.008258 | 0.010669 | 0.004843 | 0.003177 | 0.009604 | 0.012196 |
Localization Changes (T-score)
| R1 | R2 | R1 & R2 | |||||||||||||
|---|---|---|---|---|---|---|---|---|---|---|---|---|---|---|---|
| UBP2_WT | UBP14_WT | UBP2UBP14_WT | UBP2UBP14_UBP2 | UBP2UBP14_UBP14 | UBP2_WT | UBP14_WT | UBP2UBP14_WT | UBP2UBP14_UBP2 | UBP2UBP14_UBP14 | UBP2_WT | UBP14_WT | UBP2UBP14_WT | UBP2UBP14_UBP2 | UBP2UBP14_UBP14 | |
| Actin | 4.71 | 4.06 | 5.45 | 3.56 | 4.65 | 1.15 | 1.75 | -3.04 | -4.10 | -4.56 | 4.15 | 3.18 | 1.82 | -2.68 | -1.50 |
| Bud Neck | 3.61 | -3.26 | -3.17 | -5.00 | 1.36 | 3.10 | -4.04 | -0.34 | -3.64 | 3.86 | 3.67 | -4.87 | -3.10 | -6.06 | 3.19 |
| Bud Site | 2.45 | -1.66 | -2.11 | -5.12 | -0.02 | 1.06 | -5.24 | -4.33 | -4.53 | -2.23 | 1.82 | -4.74 | -5.67 | -6.37 | -1.38 |
| Cell Periphery | 8.47 | 6.73 | 8.17 | -1.10 | 3.75 | 1.53 | 1.42 | -1.24 | -2.22 | -2.22 | 5.81 | 4.67 | 3.48 | -2.45 | -0.46 |
| Cytoplasm | 2.09 | 1.57 | -0.22 | -2.79 | -2.17 | 2.64 | -2.29 | -3.04 | -3.24 | -2.69 | 2.38 | -0.17 | -3.29 | -4.08 | -3.31 |
| Cytoplasmic Foci | -21.24 | -5.81 | -12.50 | 8.47 | -7.15 | -11.06 | -15.51 | 15.77 | 26.89 | 26.14* | -18.70 | -9.91 | 5.14 | 25.02 | 14.38 |
| Eisosomes | 7.80 | 8.17 | 8.97 | 5.88 | 4.07 | 7.39 | 9.58 | 4.50 | -1.37 | -3.51 | 10.10 | 11.42 | 10.66 | 2.34 | -0.27 |
| Endoplasmic Reticulum | 5.91 | 3.25 | 5.12 | -1.08 | 4.11 | 3.92 | -0.78 | 1.72 | -2.09 | 2.34 | 6.85 | 0.28 | 4.65 | -1.93 | 5.25 |
| Endosome | 0.46 | 10.24 | -15.02 | -20.55 | -33.18* | 4.45 | 0.16 | 10.47 | 7.06 | 8.55 | 5.79 | 11.31 | -2.70 | -9.59 | -14.95 |
| Golgi | 4.92 | -4.96 | 15.83 | 17.30 | 26.94* | 0.61 | 15.96 | -18.33 | -20.26 | -30.47* | 2.09 | 1.25 | -0.92 | -3.20 | -2.05 |
| Lipid Particles | 0.82 | -0.52 | 0.84 | -0.01 | 1.88 | 5.37 | -4.28 | 7.97 | 4.08 | 10.11 | 4.93 | -2.73 | 6.77 | 2.79 | 9.75 |
| Mitochondria | 5.85 | 7.26 | 6.77 | 3.43 | -3.96 | 3.82 | 6.73 | 8.42 | 5.96 | 1.02 | 7.09 | 10.99 | 10.87 | 6.80 | -1.08 |
| Mitotic Spindle | -1.06 | -6.20 | -8.23 | -7.84 | -4.14 | -1.37 | -5.74 | -3.60 | -2.00 | 4.47 | -1.82 | -8.22 | -8.93 | -7.84 | 0.69 |
| None | 7.82 | 5.93 | 7.18 | -1.70 | 1.74 | 1.78 | 2.86 | 1.23 | -0.55 | -1.39 | 3.41 | 3.78 | 2.73 | -0.77 | -0.82 |
| Nuclear Periphery | 1.20 | -1.05 | 0.03 | -8.78 | 2.64 | -0.13 | -4.46 | -2.08 | -2.02 | 2.93 | 1.19 | -4.52 | -1.59 | -6.12 | 4.13 |
| Nuclear Periphery Foci | 1.12 | -1.87 | -1.97 | -7.05 | 0.12 | 2.00 | -4.50 | -1.03 | -2.43 | 4.09 | 1.71 | -5.18 | -3.66 | -7.38 | 2.95 |
| Nucleolus | 1.60 | 0.45 | -2.16 | -2.83 | -2.38 | 1.31 | 1.03 | 1.38 | 0.59 | 1.79 | 1.37 | 1.16 | 1.14 | -1.85 | -0.15 |
| Nucleus | 1.19 | 1.18 | 1.17 | -2.84 | -2.02 | 1.29 | 0.89 | -0.93 | -1.39 | -1.27 | 1.42 | 1.36 | 0.69 | -1.48 | -1.35 |
| Peroxisomes | -1.60 | 1.41 | -2.37 | -0.69 | -3.81 | 1.77 | 2.33 | 4.81 | 2.81 | 2.90 | 1.69 | 3.83 | 3.43 | 1.82 | -0.72 |
| Vacuole | 2.69 | -6.65 | -12.43 | -18.18 | -6.17 | -0.64 | -10.80 | -12.47 | -12.28 | 1.18 | 1.89 | -14.43 | -19.69 | -21.48 | -3.03 |
| Vacuole Periphery | 4.53 | -1.31 | -3.46 | -10.89 | -2.68 | 0.86 | -5.36 | -9.41 | -10.35 | -2.34 | 3.81 | -6.77 | -10.73 | -15.01 | -3.15 |
Endocytosis
| Temp | Actin Patch (Sac6-tdTomato) | Cortical Patch (Sla1-GFP) | Late Endosome (Snf7-GFP) | Vacuole (Vph1-GFP) |
|---|---|---|---|---|
| 37℃ | ||||
| RT |
Cell Cycle Omics
CYCLoPs (Dop1-GFP)
| Gene / Allele | Actin Patch (Sac6-tdTomato) | Cortical Patch (Sla1-GFP) | Late Endosome (Snf7-GFP) | Vacuole (Sac6-tdTomato) |
|---|
| Gene | Images |
|---|
| Gene | Images |
|---|
Images are not yet available
Images are not yet available